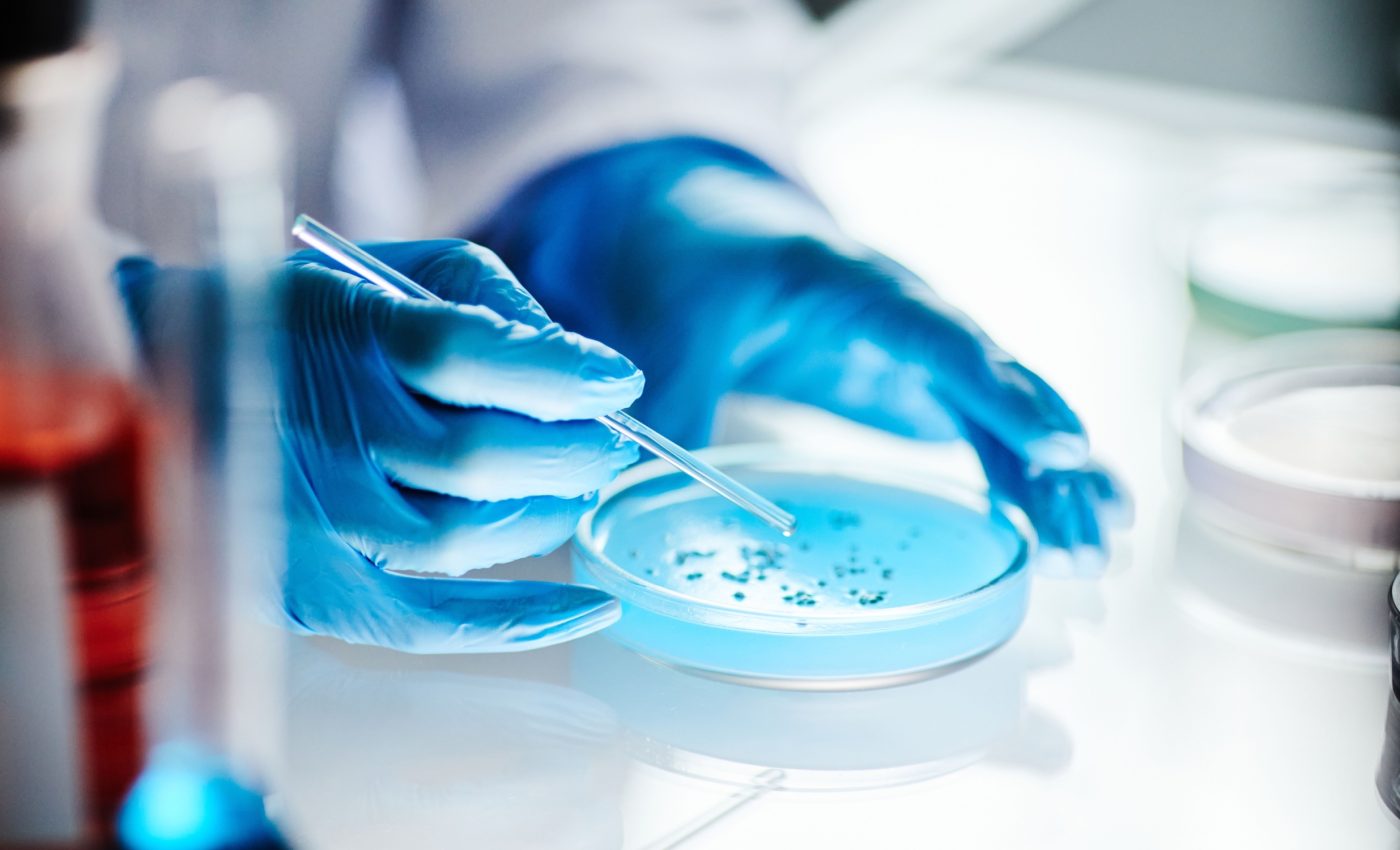

Medical science has come a long way, but heart disease continues to take a heavy toll. It remains the leading cause of death in the United States, responsible for one in every five deaths.
While medications and surgeries help manage symptoms, they don’t reverse the underlying damage – prompting scientists to explore bold new frontiers, including space.
The heart has a limited ability to regenerate, and once its muscle tissue is injured, there’s no going back. That makes the road to recovery steep, especially for patients in the final stages of heart failure.
For many, a heart transplant is the only hope — but donor hearts are few, and the waitlist grows. That reality has led scientists to explore regenerative medicine, and among the most promising areas is cardiac cell therapy.
At Emory University, researcher Chunhui Xu asked a question few had considered: What if space could help us heal the human heart?
Inspired by an eye-opening seminar on space-based research, Xu discovered that cancer cells exposed to microgravity tend to grow faster and live longer. This wasn’t just fascinating – it hinted at a game-changing possibility.
If heart cells could respond in the same way, it might offer a solution to two critical problems in cardiac cell therapy: low production rates and poor survival after transplantation.
Xu’s lab turned this hypothesis into a series of experiments. After initial ground-based tests using simulated microgravity showed promise, they sent actual heart cells into orbit. Twice.
The research centered on a specific type of cell: cardiomyocytes derived from human induced pluripotent stem cells (hiPSC-CMs). These cells offer something extraordinary.
They can be generated in large numbers and have the potential to restore heart function. In animal studies, they’ve already shown that they can improve heart performance and even act like a biological pacemaker.
Yet despite their promise, hiPSC-CMs face a significant challenge. When introduced into damaged heart tissue, most of them die. Stressful conditions such as low oxygen levels in the heart make survival difficult. Since each patient may require over a billion cells, this poor survival rate becomes a major barrier.
Improving these cells’ ability to thrive in hostile environments has become a key focus for researchers. Xu believed that space might hold the key.
Xu’s team partnered with the ISS National Laboratory and launched cardiac spheroids to the International Space Station through the SpaceX Crew-8 mission.
These 3D cell structures, derived from hiPSCs, were thawed on Earth, then cultured in microgravity aboard the ISS for eight days.
While on the ISS, astronauts successfully maintained the beating spheroids, then returned them to Earth for detailed analysis. Remarkably, the cells maintained normal beating activity and calcium signaling, critical indicators of healthy cardiac function.
But the real discovery came through molecular analysis. Spaceflight had profoundly changed these cells on the inside.
Upon their return, scientists used 3D live imaging and omics analysis to examine the cells’ inner workings.
They found that spaceflight caused significant shifts in both protein levels and gene expression. Proteins linked to metabolism, mitochondrial function, and cell survival were all elevated.
Among the top upregulated proteins were those involved in handling cellular stress and enhancing survival.
At the genetic level, the space-exposed cells showed increased activity in pathways tied to cardiac development, mitochondrial health, and essential metabolic functions like glutathione and glycerolipid metabolism.
These changes are not just academic. They indicate that spaceflight makes these cells stronger, more adaptable, and better suited for survival in the harsh environment of a failing heart.
The microgravity of the ISS alters how cells behave. Previous studies had shown that stem cells can grow faster, differentiate more easily, and even gain therapeutic traits when cultured in orbit. Xu’s findings fit this pattern and push the field forward.
“The space environment provides an amazing opportunity for us to study cells in new ways,” said Xu.
“Our research on the ISS could allow us to develop a new strategy to generate cardiac cells more efficiently with improved survival when transplanted into damaged heart tissue, which would greatly benefit patients on Earth.”
That’s the true power of this research – not just stronger cells, but a new approach to therapy. By leveraging spaceflight, scientists can create heart cells that are better equipped to survive transplantation, potentially transforming cardiac treatment altogether.
The implications of this work go far beyond the lab. If space-grown cardiac cells can survive and thrive where ordinary ones fail, they may become the foundation of a new era in regenerative medicine.
Patients once facing a lifetime of medications or the uncertainty of a transplant might one day receive engineered heart tissue – grown in orbit, prepared for life on Earth.
Xu’s research stands at the intersection of hope and innovation. With each experiment, she and her team bring us closer to a future where damaged hearts can heal – not through machines or donors, but with the body’s own cells, shaped by the weightlessness of space.
The study is published in the journal Biomaterials.
—–
Like what you read? Subscribe to our newsletter for engaging articles, exclusive content, and the latest updates.
Check us out on EarthSnap, a free app brought to you by Eric Ralls and Earth.com.
—–
